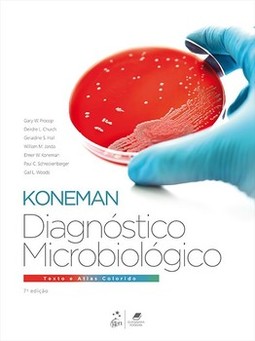

CADASTRE-SE
DIAGNÓSTICO MICROBIOLÓGICO: TEXTO E ATLAS COLORIDO
Gary W. Procop , Deirdre L. Church , Geraldine S. Hall , William M. Janda , Elmer W. Koneman , Paul C. Schreckenberger , Gail L. Woods (0) votos | (0) comentários
Sinopse
"Diagnóstico Microbiológico - Texto e Atlas" é uma fonte abrangente e de fácil compreensão, que proporciona cobertura atualizada sobre bacteriologia, micologia, parasitologia e virologia, além de um atlas com imagens de alta qualidade. Foram incorporados, nesta edição, os avanços substanciais que ocorreram na área da microbiologia clínica desde a edição anterior, como a espectrometria de massa MALDI-TOF e os testes de amplificação do ácido nucleico de fácil realização. O livro é uma referência para alunos, professores e profissionais de laboratório.
Principais características:
Correlações clínicas: os Quadros de Correlações Clínicas fazem uma ponte entre os microrganismos e as doenças a eles relacionadas por meio da utilização da mais atual literatura médica.
Quadros clínicos são utilizados para demonstrar como a microbiologia é aplicada em situações reais.
Pranchas coloridas ilustram microrganismos de relevância de modo a auxiliar em sua identificação.
Esquemas são usados como diretrizes práticas para a avaliação clinicamente relevante e de melhor custo–eficácia das amostras clínicas.
| Categoria | |
| Editora | Grupo GEN |
| ISBN-13 | 9788527733182 |
| ISBN | 8527733188 |
| Edição | 7 / 2018 |
| Idioma | Português |
| Páginas | 1860 |
| Estante | 0 0 0 0 |
| Sua estante | |
8% chance de ser solicitado
CADASTRE-SE
AVALIAÇÃO DO LEITOR
Quero comentar sobre este livro